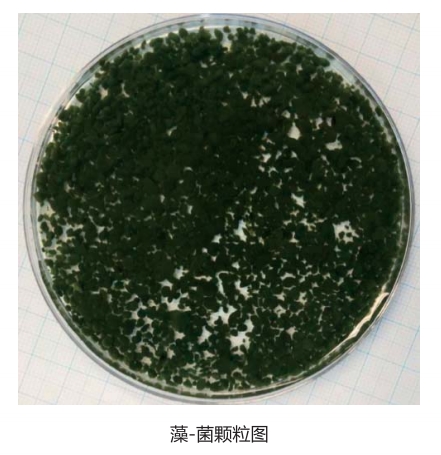
1.png 1.png

傳統市政污水處理工藝基于生物氧化原理,面臨能耗大、溫室氣體排放量大、資源回收效率低等挑戰。近年 來(lái),低碳污水生物處理技術(shù)團隊圍繞我國城市水體污染治理領(lǐng)域的低碳污水生物處理、水生態(tài)修復與自?xún)裟芰?復等重大需求開(kāi)展研究,開(kāi)發(fā)了藻-菌顆粒工藝。該工藝是傳統污水生物處理的顛覆,在污水處理過(guò)程中不依賴(lài)于 曝氣,靠光驅動(dòng)、不產(chǎn)生溫室氣體。處理污水時(shí)可采用多種模式如連續光照模式、連續黑暗模式和黑暗-光照交替 運行模式進(jìn)行,可在不同季節和不同天氣的情況下實(shí)現在任意周期內達到污染物去除效果的目的。該工藝對生活 污水中生化需氧量(COD)、 氨氮和磷酸鹽的去除率分別高達81.2-95.1%、89.1%-98.7%和66.7-96.7%,出 水水質(zhì)可達到《GB18918-2002》 一級A 標準;處理生活污水產(chǎn)生的藻-菌生物質(zhì)可進(jìn)一步被利用生產(chǎn)生物肥料 生物氣、生物柴油和生物炭等。
應用范圍
藻-菌顆粒工藝展現出低碳、低耗、高效等優(yōu)勢,有潛力同步回收水、能源和資源,是未來(lái)市政污水面向環(huán)境 可持續處理和再生回用提供了新選擇。該技術(shù)可用于主流市政污水處理、污水處理廠(chǎng)提標改造、湖泊水體修復 等,具有成本低、效益高、零污染等特點(diǎn)。